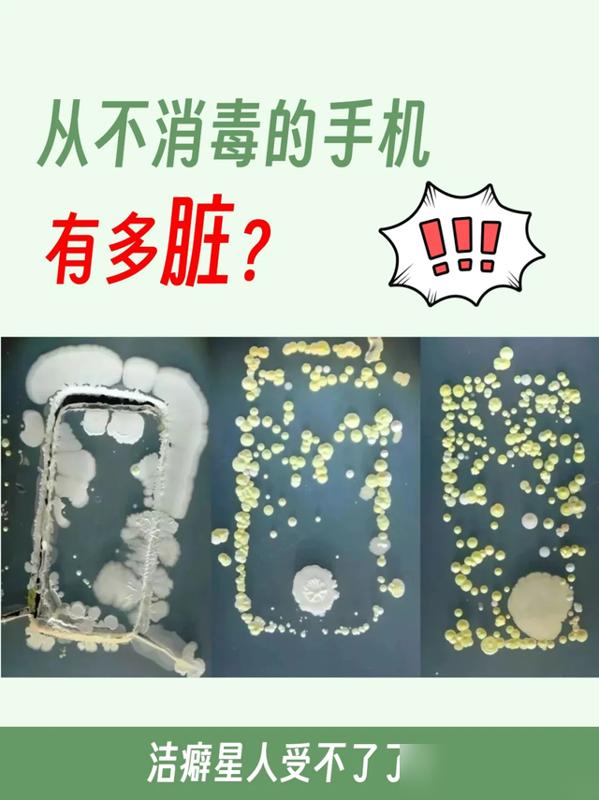

细思极恐!天天攥在手里的手机、天天用的洗衣机,居然藏着比马桶还多的细菌?最近好多人聊家里那些“表面干净实则巨脏”的物品——手机细菌是马桶冲水柄18倍、洗衣机内桶黏绒毛生细菌、花洒头水垢刺激皮肤…这些天天用的东西,居然偷偷攒着“健康隐患”! 可不能再大意了!以前觉得“看着干净”就没事,现在才懂看不见的细菌才最坑人,咱得把这些卫生死角揪出来好好清! 咱们中国人最讲“防患于未然”,健康从来不是靠“碰运气”,就是把手机消毒、洗衣机半年清一次、床单两周换这些小事做到位啊! 大家平时有没有定期清洁这些地方?咱们把家里的“隐形脏东西”扫干净,就是给家人最实在的健康守护,对吧?